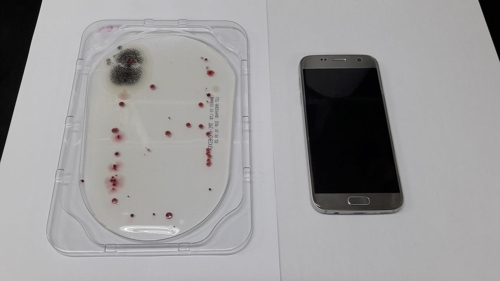

Áñ°Üã±âÃß°¡2025.11.29 ±â»óûGO

È«ÁØÇ¥ ¡°10¸¸ ½ÅõÁö ±¹Èû ÀÔ´ç...±³ÁÖ°¡ ëÅ µ½´Â´Ù´õ¶ó¡±
È«ÁØÇ¥ Àü ´ë±¸½ÃÀåÀº 2021³â ´ë¼± ±¹¹ÎÀÇÈû °æ¼± ´ç½Ã ÀÌ´Ü ½ÅõÁö ½Åµµ 10¿©¸¸¸íÀÌ ±¹¹ÎÀÇÈû ´ç¿øÀ¸·Î °¡ÀÔÇØ À±¼®¿ È常¦ ...

ì°´ëÅë·É, 8¿ù 15ÀÏ ±¤º¹Àý Çà»ç¼ ¡®±¹¹Î ÀÓ¸í½Ä¡¯
¿øº»º¸±âÀÌÀç¸í ½ÅÀÓ ´ëÅë·ÉÀÌ 4ÀÏ ¼¿ï ¿©Àǵµ ±¹È¸ ·ÎÅÙ´õȦ¿¡¼ ¿¸° ¾à½Ä ÃëÀӽĿ¡¼ ¿¬¼³ µµÁß ¹Ú¼ö¸¦ ¹Þ°í ÀÖ´Ù. &nb...

2¾ï ºô·Á°¡´õ´Ï ¿¬¶ô µÎÀý... ÀÌ·± ÀÚ½Ä ¾î¶»°Ô ÇØ¾ßÇϳª¿ä
¡°ÁýÀ» ÀÌ»çÇÏ°í ´ëÃâ °±°í ¾Öµé Çкñµµ ³»·Á¸é µ·ÀÌ ÇÊ¿äÇÏ´Ù°í ÇØ¼ ¾ÆµéÇÑÅ× 2¾ï¿øÀ» ºô·ÁÁá¾î¿ä. ±×·±µ¥ ÀÌÁ¦ ¿ì¸®°¡ ...

ÀÏÀÚ¸® ±¸Çϱâ '¹Ù´Ã±¸¸Û'¡¦±¸Á÷ÀÚ 1¸í´ç ÀÏÀÚ¸® 0.39°³
ÀÏÀÚ¸®¸¦ ã´Â »ç¶÷Àº ´Ã¾î³ª´Âµ¥ ÀÏÀÚ¸®´Â ÁÙ¾îµå´Â »óȲÀÌ Áö¼ÓÇϰí ÀÖ...

¼¿ï½Ã, Àå¾ÖÀκ¹Áö°ü ÁÖ°£È°µ¿ È®´ë¡¦±¸¸³½Ã¼³ 2°÷ Ãß°¡ °Ç¸³
³·È°µ¿ Áö¿ø»ç¾÷ µÎ ¹è·Î¡¦Áö¿ª»çȸ Á᫐ ±â´É °³Æí [¿¬ÇÕ´º½ºTV Á¦°ø] (¼¿ï=¿¬ÇÕ´º½º) °íÇö½Ç ±âÀÚ = ¼¿ï½Ã´Â ¿ÃÇØ Àå¾ÖÀκ¹Áö°üÀÇ ÁÖ°£È°µ¿À» È®´ëÇϰí, ±¸¸³½Ã¼³ µÎ °÷À» Ãß°¡·Î ¿¬´Ù. ¼¿ï½Ã´Â ÀÌ...
»çȸ | 03-21 11:55

"±â¾ïÇÏÀÚ" À§´ëÇÑ ¿©¼ºµ¶¸³¿îµ¿°¡, Àü½Ã·Î ¸¸³ª´Ù
¼¼Á¾¹®Èȸ°ü¼ 27ÀÏ Æ¯º°±âȹÀü ¼¿ïÀü °³¸·¡¦4¿ù 9ÀϱîÁö ÁøÇà¿©¼º°¡Á·ºÎ¡¤¿¬ÇÕ´º½º °øµ¿ ÁÖÃÖ, ±¹¸³¿©¼º»çÀü½Ã°ü ÁÖ°ü Ãà»çÇÏ´Â Áø¼±¹Ì ¿©°¡ºÎ Àå°ü(°í¾ç=¿¬ÇÕ´º½º) Áø¼±¹Ì ¿©¼º°¡Á·ºÎ Àå°üÀÌ Áö³ 7ÀÏ ¿À...
»çȸ | 03-21 10:14

Çѱ¹ ¼¼°èÇູÁö¼ö 156°³±¹ Áß 54À§¡¦Çɶõµå ¶Ç 1À§
2019 ¼¼°èÇູº¸°í¼¡¦ùÛ »çȸÀû ÀÚÀ¯¡¤ºÎÁ¤ºÎÆÐ ÇÏÀ§±Ç"Àü ¼¼°è °æÁ¦¼ºÀå Áö¼Ó¿¡µµ Çູµµ´Â Àü¹ÝÀûÀ¸·Î Ç϶ô" ¼¿ï½Ã¹Î ÇູÁö¼ö ¼¼°èÁÖ¿äµµ½Ã Áß '²ÃÁö'(ÀÚ·á»çÁø)uwg806@yna.co.kr/2007-01-19 14:05:30/...
»çȸ | 03-21 10:10
´ë°Ë 'º°Àå ¼ºÁ¢´ë ÀÇȤ' ±èÇÐÀÇ Àü Â÷°ü ³»ÀÏ °ø°³¼Òȯ(Á¾ÇÕ)
2013³â °ËÂû¼ö»ç¶© ¹«ÇøÀÇ Ã³ºÐ¡¦Áø»óÁ¶»ç´Ü, Áõ°Å´©¶ô¡¤±ºÀ强 ¿¬·çµµ Á¶»ç °Ë°æ ¼ö»ç±Ç Á¶Á¤°¥µî¡¦À̹ø¿£ ±èÇÐÀÇ »ç°Ç ³õ°í Ãæµ¹ (CG)[¿¬ÇÕ´º½ºTV Á¦°ø] (¼¿ï=¿¬ÇÕ´º½º) ÀÓ¼øÇö ±âÀÚ = '±èÇÐÀÇ Àü ¹ý¹«...
»çȸ | 03-14 15:17

½Ã¹Î´Üü "¹Ú±ÙÇý źÇÙ 2³â¡¦Á¤ºÎ, ÀûÆó û»ê ÀÇÁö º¸¿©¾ß"
'¹Ú±ÙÇý ÆÄ¸é 2³â ÀûÆóû»ê »çȸ´ë°³Çõ Ã˱¸' ±âÀÚȸ°ß(¼¿ï=¿¬ÇÕ´º½º) °¹ÎÁö ±âÀÚ = 12ÀÏ ¿ÀÈÄ ¼¿ï Á¾·Î±¸ ¼¼Á¾¹®Èȸ°ü °è´Ü¿¡¼ ¿¸° '¹Ú±ÙÇý ÆÄ¸é 2³â ÀûÆóû»ê »çȸ´ë°³Çõ Ã˱¸' ¹ÎÁß°øµ¿Çൿ ±âÀÚ...
»çȸ | 03-12 16:14

ìí õÁÖ±³°è "³²ºÏºÐ´Ü ±Ù¿ø¿¡ ÀϺ» ħ·« ÀÖ¾î"
ÀϺ»°¡Å縯Á¤ÀÇ¿ÍÆòÈÇùÀÇȸÀå 3¡¤1¿îµ¿ 100Áֳ⠴ãÈ °¡¾²¾ß ´ÙÀÌÁö ÁÖ±³[Çѱ¹ÃµÁÖ±³ÁÖ±³È¸ÀÇ Á¦°ø] (¼¿ï=¿¬ÇÕ´º½º) °Á¾ÈÆ ±âÀÚ = ÀϺ» õÁÖ±³°è°¡ ÀϺ»ÀÇ Ä§·«¿¡ ´ëÇÑ Ã¥ÀÓÀ» ÀÎÁ¤ÇÏ¸ç ¿ª»ç¸¦ Á÷½ÃÇØ¾ß...
»çȸ | 03-12 16:12

Áö¿ª»çȸ ÅëÇÕµ¹º½ ¼±µµ»ç¾÷¿¡ 29°³ ÁöÀÚü ½Åû
º¹ÁöºÎ, ³ëÀΡ¤Àå¾ÖÀΡ¤Á¤½ÅÁúȯÀÚ ´ë»ó »ç¾÷Áö¿ª 8°÷ 4¿ù ¼±Á¤ (¼¿ï=¿¬ÇÕ´º½º) ½ÅÀç¿ì ±âÀÚ = º¸°Çº¹ÁöºÎ´Â Áö¿ª»çȸ ÅëÇÕµ¹º½ ¼±µµ»ç¾÷ ¼öÇà ±âÃÊÀÚÄ¡´Üü¸¦ °ø¸ðÇÑ °á°ú, ºÎ»ê ºÏ±¸¿Í ±¤ÁÖ ¼±¸ µî 29°³ Áö...
»çȸ | 03-12 16:09
"ÈÞ´ëÀüÈ¿¡ ½ÄÁßµ¶±Õ µæ½Ç"¡¦116´ë Áß 37´ë¼ °ËÃâ
´ëÀüº¸°Çȯ°æ¿¬±¸¿ø "¿Ã¹Ù¸¥ ¼Õ ¾Ä±â¿Í ÁÖ±âÀûÀÎ ÈÞ´ëÀüÈ ¼Òµ¶ ÇÊ¿ä" ½ÄÁßµ¶±Õ¿¡ ¿À¿°µÈ ÈÞ´ëÀüÈ[´ëÀü½Ã Á¦°ø] (´ëÀü=¿¬ÇÕ´º½º) Á¤À±´ö ±âÀÚ = ´ëÀüÁö¿ª û¼Ò³âµéÀÌ °®°í ´Ù´Ï´Â ÈÞ´ëÀüÈ »ó´ç¼ö¿¡¼ ½Ä...
»çȸ | 03-12 10:07

[3¤ý1¿îµ¿.ÀÓÁ¤ ÛÝÁÖ³â](44) 2´ë °ÉÃÄ ´ëÇѵ¶¸³ Áö¿ø ÇÇÄ¡¸ñ»çÊ«
Á¶Áö Çʵå ÇÇÄ¡ ¿©¿îÇü ¸¸³ª ÇÑÀÎÀÇ ºñÂüÇÑ Çö½Ç ÀÚ°¢ Á¶Áö ¾Ö½¬¸ð¾î ÇÇÄ¡ ºÎºÎ ±è±¸ ¼±»ý Å»Ãâ¿¡ °áÁ¤Àû µµ¿òÇÇÄ¡ ¸ñ»ç ±â·Á °Ç¸³µÈ ÈË´õÅÁ ±³È¸ »óÇÏÀÌ µÖ·é·ç ¸í¹° Á¶Áö Çʵå ÇÇÄ¡ ¸ñ»ç ±â¸®´Â »óÇÏÀÌ ±³...
»çȸ | 03-12 09:48

"°øÇ×¼ Ãâ±¹ Æí¸®ÇØÁø´Ù"¡¦Áö¹®¡¤Á¤¸Æ ¸¸À¸·Î ½Å¿øÈ®ÀÎ
»ó¹Ý±â ÀÔ±¹Àå ¸é¼¼Á¡ µµÀÔ¡¦°øÇסȣÅÚ ¼öÇϹ° À§Å¹ ¼ºñ½ºµµ (¼¼Á¾=¿¬ÇÕ´º½º) ±èµ¿±Ô ±âÀÚ = À̸£¸é ¿ÃÇØ ¾È¿¡ ½ÅºÐÁõ ¾øÀ̵µ °øÇ׿¡¼ Áö¹®°ú ¼Õ¹Ù´Ú Á¤¸Æ µî »ýüÁ¤º¸¸¦ ÅëÇØ ½Å¿øÀ» È®ÀÎÇϰí ÇØ¿Ü·Î Ãâ±¹ÇÏ...
»çȸ | 03-07 15:26
¹ÚÁø¿µ JYP¿£ÅÍÅ×ÀÎ¸ÕÆ® ´ëÇ¥ ÇÁ·Îµà¼°¡ 9ÀÏ ´ëÅë·É Á÷¼Ó ´ëÁß¹®È±³·ù...
°¡¼ö À¯½ÂÁØ(48¡¤¹Ì±¹ À̸§ ½ºÆ¼ºê ½ÂÁØ À¯)¾¾ÀÇ ºñÀÚ ¹ß±ÞÀ» µÑ·¯½Ñ ¼¼ ¹øÂ°...
±×·ì ¹æÅº¼Ò³â´Ü(BTS) ¸â¹ö Àü¿øÀÇ ±º º¹¹« Á¾·á¿Í Àç°áÇÕ¿¡ ¿Ü...
ȸ»ñµ· 43¾ï¿øÀ» Ⱦ·ÉÇÑ ÇøÀÇ·Î ±â¼ÒµÈ ¹è¿ì ȲÁ¤À½ÀÌ Àç»êÀ» óºÐÇØ ...
°æÂûÀÌ ½ÅûÇÑ ¹æ½ÃÇõ ÇÏÀ̺ê ÀÇÀåÀÇ ÀÚº»½ÃÀå¹ý À§¹Ý ÇøÀÇ¿Í °ü·ÃÇÑ ...
»óÈ£: ¿µ³²¸ÅÀϽŹ®(ÁÖ) | »ç¾÷ÀÚµî·Ï¹øÈ£: 506-81-85807 | ´ëÇ¥: °È£¼º | ½Å¹®µî·Ï¹øÈ£ : ºÎ»ê °¡00021 / ÀÎÅͳݽŹ®µî·Ï¹øÈ£ : ºÎ»ê, ¾Æ00272
ÀüÈ: 051-867-3909 | ÆÑ½º: 051-861-3463 | ÁÖ¼Ò: ºÎ»ê±¤¿ª½Ã ¿¬Á¦±¸ Áß¾Ó´ë·Î 1111, 1701È£ (¿¬»êµ¿, À§µåŸ¿ö)
copyright ¨Ï 2015 newsyn.co.kr All right reserved. | web@newsyn.co.kr